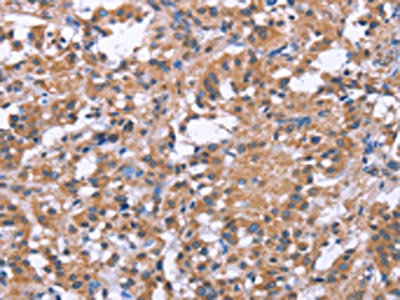

SLC52A1 Antibody
-
中文名稱:SLC52A1兔多克隆抗體
-
貨號:CSB-PA977414
-
規(guī)格:¥1100
-
圖片:
-
The image on the left is immunohistochemistry of paraffin-embedded Human thyroid cancer tissue using CSB-PA977414(SLC52A1 Antibody) at dilution 1/40, on the right is treated with synthetic peptide. (Original magnification: ×200)
-
The image on the left is immunohistochemistry of paraffin-embedded Human gastric cancer tissue using CSB-PA977414(SLC52A1 Antibody) at dilution 1/40, on the right is treated with synthetic peptide. (Original magnification: ×200)
-
-
其他:
產(chǎn)品詳情
-
Uniprot No.:
-
基因名:SLC52A1
-
別名:FLJ10060 antibody; G protein coupled receptor 172B antibody; GPCR antibody; GPCR42 antibody; hRFT1 antibody; member 1 antibody; OTTHUMP00000125300 antibody; PAR2 antibody; PERV-A receptor 2 antibody; PERVA receptor 2 antibody; Porcine endogenous retrovirus A receptor 2 antibody; Protein GPR172B antibody; Putative G protein coupled receptor GPCR42 antibody; Riboflavin transporter 1 antibody; riboflavin transporter antibody; S52A1_HUMAN antibody; SLC52A1 antibody; Solute carrier family 52 antibody; Solute carrier family 52, riboflavin transporter, member 1 antibody
-
宿主:Rabbit
-
反應(yīng)種屬:Human
-
免疫原:Synthetic peptide of Human SLC52A1
-
免疫原種屬:Homo sapiens (Human)
-
標(biāo)記方式:Non-conjugated
-
抗體亞型:IgG
-
純化方式:Antigen affinity purification
-
濃度:It differs from different batches. Please contact us to confirm it.
-
保存緩沖液:-20°C, pH7.4 PBS, 0.05% NaN3, 40% Glycerol
-
產(chǎn)品提供形式:Liquid
-
應(yīng)用范圍:ELISA,IHC
-
推薦稀釋比:
Application Recommended Dilution ELISA 1:2000-1:5000 IHC 1:50-1:200 -
Protocols:
-
儲存條件:Upon receipt, store at -20°C or -80°C. Avoid repeated freeze.
-
貨期:Basically, we can dispatch the products out in 1-3 working days after receiving your orders. Delivery time maybe differs from different purchasing way or location, please kindly consult your local distributors for specific delivery time.
-
用途:For Research Use Only. Not for use in diagnostic or therapeutic procedures.
相關(guān)產(chǎn)品
靶點詳情
-
功能:Plasma membrane transporter mediating the uptake by cells of the water soluble vitamin B2/riboflavin that plays a key role in biochemical oxidation-reduction reactions of the carbohydrate, lipid, and amino acid metabolism. Humans are unable to synthesize vitamin B2/riboflavin and must obtain it via intestinal absorption.; (Microbial infection) May function as a cell receptor to retroviral envelopes similar to the porcine endogenous retrovirus (PERV-A).
-
基因功能參考文獻(xiàn):
- We here report a case of transient MADD, caused by a heterozygous intronic variation, c.1134+11G>A, in the SLC52A1 gene encoding RFVT1. This variation creates a binding site for the splice inhibitory hnRNP A1 protein and causes exon 4 skipping. Riboflavin deficiency and maternal malnutrition during pregnancy might have been the determining factor in the outcome of this case. PMID: 29122468
- In HT-29 cells, the RFVT1 protein level was drastically lower. In tumor tissues of patients with CRC, RFVT1 content was reduced at both protein and mRNA levels compared to normal mucosa. PMID: 29715086
- results are the first to reveal the identity of the minimal SLC52A1 promoter and to establish an important role for Sp-1 in its activity PMID: 25284511
- data suggest that MMND is a distinct clinical subgroup of childhood onset MND patients where the known genetic defects are so far negative. PMID: 24139842
- summary of recent findings on the cloning, nomenclature, functional characterization and genetic diseases of RFVT1/SLC52A1, RFVT2/SLC52A2 and RFVT3/SLC52A3 [review] PMID: 23506902
- Intestinal riboflavin uptake process undergoes differentiation-dependent upregulation and suggest that this is mediated (at least in part) via transcriptional mechanisms of SLC52A1 and SLC52A3. PMID: 23413253
- We demonstrated that TFAP-2gamma is one of the transcription factors involved in the PAR-2 expression in human villous trophoblast cells. PMID: 22702469
- Identification/characterization riboflavin trasporter (RFT1) as a novel riboflavin transporter. PMID: 18632736
顯示更多
收起更多
-
相關(guān)疾病:Riboflavin deficiency (RBFVD)
-
亞細(xì)胞定位:Cell membrane; Multi-pass membrane protein.
-
蛋白家族:Riboflavin transporter family
-
組織特異性:Widely expressed. Highly expressed in the testis, placenta and small intestine. Expressed at lower level in other tissues.
-
數(shù)據(jù)庫鏈接:
Most popular with customers
-
-
YWHAB Recombinant Monoclonal Antibody
Applications: ELISA, WB, IHC, IF, FC
Species Reactivity: Human, Mouse, Rat
-
-
-
-
-
-